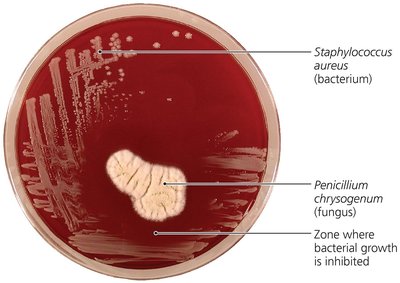
Penicillium chrysogenum inhibiting Staphylococcus aureus on agar plate

BackControlling Microbial Growth in the Body: Antimicrobial Drugs
Study Guide - Smart Notes
Tailored notes based on your materials, expanded with key definitions, examples, and context.
Controlling Microbial Growth in the Body: Antimicrobial Drugs
The History of Antimicrobial Agents
Antimicrobial drugs are essential tools in the treatment of infectious diseases. Their development has revolutionized medicine and public health.
Drugs: Chemicals that affect physiology in any manner.
Chemotherapeutic agents: Drugs that act against diseases.
Antimicrobial agents (antimicrobials): Drugs that treat infections caused by microorganisms.
Key historical figures:
Paul Ehrlich: Proposed the concept of "magic bullets"—chemicals that selectively target pathogens. Developed arsenic compounds effective against microbes.
Alexander Fleming: Discovered penicillin, the first true antibiotic, produced by the fungus Penicillium chrysogenum.
Gerhard Domagk: Discovered sulfanilamide, the first widely used synthetic antimicrobial.
Selman Waksman: Coined the term "antibiotics" for antimicrobial agents produced naturally by organisms.
Semisynthetics: Chemically modified antibiotics that are more effective, longer lasting, or easier to administer than natural antibiotics.
Synthetics: Antimicrobials synthesized entirely in the laboratory.
Sources of Common Antibiotics and Semisynthetics
Antibiotics and their derivatives are produced by a variety of microorganisms, including fungi and bacteria. The following table summarizes some important sources and their corresponding antimicrobials.
Microorganism | Antimicrobial |
|---|---|
Fungi | |
Penicillium chrysogenum | Penicillin G |
Penicillium griseofulvum | Griseofulvin |
Acremonium spp. | Cephalosporin |
Bacteria | |
Amycolatopsis orientalis | Vancomycin |
Amycolatopsis rifamycinica | Rifampin |
Bacillus licheniformis | Bacitracin |
Bacillus polymyxa | Polymyxin |
Micromonospora purpurea | Gentamicin |
Streptomyces spp. | Multiple antibiotics (e.g., Streptomycin, Tetracycline, Chloramphenicol, Amphotericin B, Ivermectin) |

Mechanisms of Antimicrobial Action
Antimicrobial drugs work by targeting specific structures or functions in microbial cells. The principle of selective toxicity is crucial: drugs should harm the pathogen more than the host.
Antibacterial drugs are the most numerous and diverse.
Fewer drugs are available for treating fungal, protozoan, or viral infections due to similarities with host cells or unique viral biology.

Major Mechanisms:
Inhibition of cell wall synthesis
Inhibition of protein synthesis
Disruption of cytoplasmic membrane
Inhibition of metabolic pathways
Inhibition of nucleic acid synthesis
Inhibition of pathogen's attachment or entry into host cell
Inhibition of Cell Wall Synthesis
Many antibiotics target the synthesis of peptidoglycan, a key component of bacterial cell walls. This weakens the wall, leading to cell lysis due to osmotic pressure.
Beta-lactams (e.g., penicillins, cephalosporins, carbapenems): Bind to enzymes that cross-link NAM subunits, preventing proper cell wall formation.
Semisynthetic beta-lactams: More stable, better absorbed, less susceptible to deactivation, and broader spectrum.
Vancomycin and cycloserine: Interfere with bridges linking NAM subunits in Gram-positive bacteria.
Bacitracin: Blocks transport of NAG and NAM from cytoplasm.
Isoniazid and ethambutol: Disrupt mycolic acid formation in mycobacteria.
These drugs are effective only on growing cells, as they prevent new peptidoglycan synthesis but do not affect existing layers.

Fungal cell walls, composed of unique polysaccharides, can be targeted by drugs like echinocandins, which inhibit glucan synthesis.
Inhibition of Protein Synthesis
Antimicrobials can selectively target prokaryotic ribosomes (70S) without affecting eukaryotic ribosomes (80S), disrupting protein synthesis.
Aminoglycosides: Cause misreading of mRNA by altering 30S subunit shape.
Tetracyclines: Block docking site of tRNA on the 30S subunit.
Chloramphenicol: Blocks peptide bond formation at the 50S subunit.
Macrolides, lincosamides: Block proper movement of mRNA through the ribosome.
Antisense nucleic acids: Bind mRNA, preventing translation.
Oxazolidinones: Block initiation of translation.
Mupirocin: Inhibits isoleucyl-tRNA synthetase, preventing isoleucine incorporation in Gram-positive bacteria.

Disruption of Cytoplasmic Membranes
Some drugs compromise the integrity of microbial membranes, leading to cell death.
Polyenes (e.g., nystatin, amphotericin B): Bind to ergosterol in fungal membranes, forming pores and causing leakage.
Azoles and allylamines: Inhibit ergosterol synthesis in fungi.
Polymyxin: Disrupts membranes of Gram-negative bacteria; toxic to human kidneys.
Some antiparasitic drugs also target cytoplasmic membranes.

Inhibition of Metabolic Pathways
Antimetabolic agents exploit differences between host and pathogen metabolism.
Sulfonamides: Structural analogs of PABA, inhibit folic acid synthesis in bacteria and protozoa.
Trimethoprim: Inhibits a later step in folic acid synthesis.
Atovaquone: Disrupts electron transport in protozoa and fungi.
Heavy metals: Inactivate enzymes.
Antiviral agents: Amantadine and rimantadine prevent viral uncoating; protease inhibitors block HIV replication.

Inhibition of Nucleic Acid Synthesis
Some drugs block DNA replication or RNA transcription, but these often affect both prokaryotic and eukaryotic cells, limiting their use to research or cancer therapy.
Quinolones and fluoroquinolones: Inhibit prokaryotic DNA gyrase.
Nucleotide/nucleoside analogs: Distort nucleic acid structures, preventing replication, transcription, or translation; used mainly against viruses and some cancers.
Inhibitors of RNA polymerase: Block transcription.
Reverse transcriptase inhibitors: Target HIV replication; do not harm humans as we lack reverse transcriptase.

Example: Acyclovir is a nucleoside analog used to treat herpesvirus infections by inhibiting viral DNA synthesis.